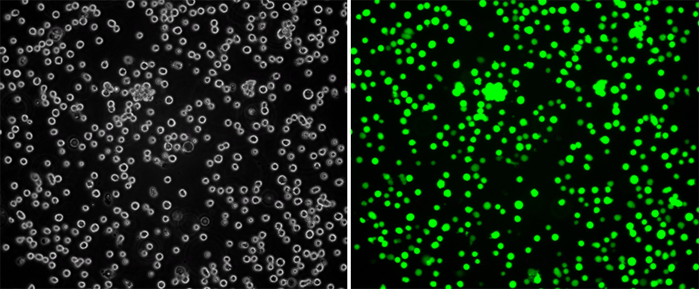

GFP/Raji Stable Cell Line
Fig-1: Analysis of the GFP/Raji stable cell line through fluorescence microscopy. Bright-field image (Left); Fluorescence image (Right).
Roll over image to zoom in
Shipping Info:
Order now and get it on Thursday July 31, 2025
Same day delivery FREE on San Diego area orders placed by 1.00 PM
Amount : | 1 vial |
Content : | Each vial contains 2 ~ 3 x 10^6 cells in 1 ml of 90% FBS + 10% DMSO |
Storage condition : | Immediately upon receipt, store in liquid nitrogen. |
GFP/Raji Stable Cell Line is a stably transfected Raji cell line which expresses enhanced green fluorescent protein (eGFP).
Sequence data: Amino acid sequence of eGFP
Application:.
- Screen for GFP through Flow Cytometry.
- Screen for GFP through Fluorescence Microscopy.
Culture conditions:
LIMITED USE RESTRICTIONS:
THIS PRODUCT IS SOLELY FOR IN VITRO RESEARCH USE ONLY. NOT FOR DIAGNOSTIC OR THERAPEUTIC USE.
By use of this product, user agrees to be bound by the terms of this limited use statement.
This product is solely for Internal Research Purposes and not for Commercial Purposes. Commercial Purposes include, but are not limited to (1) use of the cell line in manufacturing; (2) use of the cell line to provide a service, information or data; (3) use of the cell line for therapeutic, diagnostic or prophylactic purposes; or (4) resale of the cell line whether or not such cell lines are resold for use in research. The buyer cannot sell, give or otherwise transfer this product to a third party.
Commercial License Agreement is available for non-research use if applicable. Please contact Abeomics ([email protected]).
For Research Use Only. Not for use in diagnostic/therapeutics procedures.
There are currently no product reviews
|